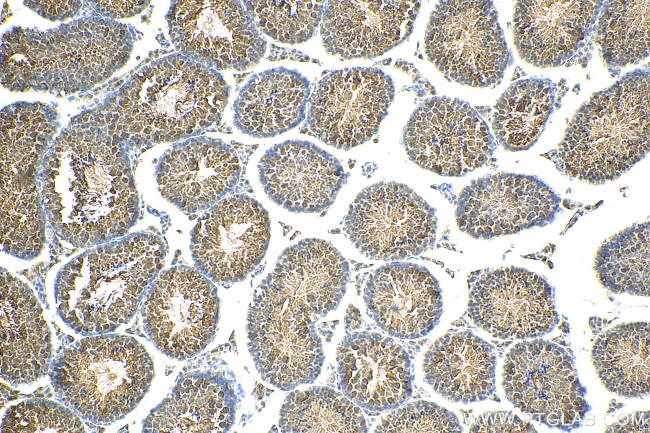
FBXW5 Antibody in Immunohistochemistry (Paraffin) (IHC (P))

Search
Proteintech
FBXW5 Polyclonal Antibody
{{$productOrderCtrl.translations['antibody.pdp.commerceCard.promotion.promotions']}}
{{$productOrderCtrl.translations['antibody.pdp.commerceCard.promotion.viewpromo']}}
{{$productOrderCtrl.translations['antibody.pdp.commerceCard.promotion.promocode']}}: {{promo.promoCode}} {{promo.promoTitle}} {{promo.promoDescription}}. {{$productOrderCtrl.translations['antibody.pdp.commerceCard.promotion.learnmore']}}
产品信息
18321-1-AP
种属反应
已发表种属
宿主/亚型
分类
类型
抗原
偶联物
形式
浓度
规格
纯化类型
保存液
内含物
保存条件
运输条件
产品详细信息
Immunogen sequence: VLWLNNAFQ DVESENVNVV KRLFKIQNLN ASTVRTVMVA DCSRFDSPDL LLEAGDPATS PCRIFDLGSD NEEVVAGPAP AHAKEGLRHF LDRVLEGRAQ PQLSERMLET KVAELLAQGH TKPPERSATG AKSKYLIFTT GCLTYSPHQI GIKQILPHQM TTAGPVLGEG RGSDAFFDAL DHVIDIHGHI IGMGLSPDNR YLYVNSRAWP NGAVVADPMQ PPPIAEEIDL LVFDLKTMRE VRRALRAHRA YTPNDECFFI FLDVSRDFVA SGAEDRHGYI WDRHYNICLA RLRHEDVVNS VVFSPQEQEL LLTASDDATI KAWRSPRTMR VLQAPRPRPR TFFSWLASQR R (217-566 aa encoded by BC014297)
靶标信息
This gene encodes a member of the F-box protein family, members of which are characterized by an approximately 40 amino acid motif, the F-box. The F-box proteins constitute one of the four subunits of ubiquitin protein ligase complex called SCFs (SKP1-cullin-F-box), which function in phosphorylation-dependent ubiquitination. The F-box proteins are divided into three classes: Fbws containing WD-40 domains, Fbls containing leucine-rich repeats, and Fbxs containing either different protein-protein interaction modules or no recognizable motifs. The protein encoded by this gene contains WD-40 domains, in addition to an F-box motif, so it belongs to the Fbw class. Alternatively spliced transcript variants encoding distinct isoforms have been identified for this gene, however, they were found to be nonsense-mediated mRNA decay (NMD) candidates, hence not represented.
仅用于科研。不用于诊断过程。未经明确授权不得转售。
生物信息学
蛋白别名: F-box and WD-40 domain protein 5; F-box and WD-40 domain-containing protein 5; F-box protein Fbw5; F-box/WD repeat-containing protein 5; unnamed protein product; WD repeat-containing F-box protein FBW5
基因别名: AI159739; FBW5; FBXW5; PP3971
UniProt ID: (Human) Q969U6, (Mouse) Q9QXW2, (Rat) Q4KLI9
Entrez Gene ID: (Human) 54461, (Mouse) 30839, (Rat) 362081